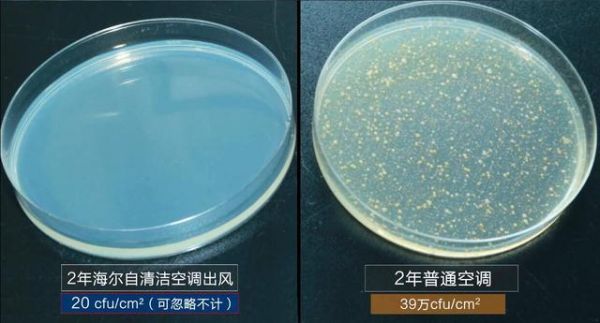

中科院细菌实验揭秘:夏天不敢乱开空调,原因都在这了!
6月2日,山东省气象台发布今年首个高温黄色预警,预计未来三天,全省多个城市的部分地区最高气温可达37℃以上。高温季来临,许多家庭面临着这样的疑惑:家里空调能开吗?开空调会存在防疫隐患吗?
对此,专家建议,家用空调和各种场所内的空调,在使用前最好进行清洁消毒。空调清洗消毒不仅降低了病毒传播的风险,由于脏空调极易滋生细菌,清洗空调还能减少细菌污染。早在2017年,中科院就曾对普通空调蒸发器和海尔自清洁空调蒸发器进行采样,做了3组空调细菌对比实验:
第一组实验对空调本身细菌含量进行测试。结果显示,使用2年的海尔自清洁空调细菌数为20cfu/cm2,可忽略不计;而使用2年普通空调细菌数高达39万cfu/cm2。
第二组进行了空调抗菌性能实验。实验员对两台空调消毒杀菌后,向蒸发器表面喷洒细菌。经过取样培养测试,普通空调蒸发器细菌高达5.4万cfu/cm2,而海尔自清洁空调蒸发器细菌数均小于10cfu/cm2。

第三组实验对脏空调出风细菌含量进行了测试。通过对两台空调出风口取样,经细菌培养和计数后发现,普通空调出风口向空气中传播大量细菌,而海尔自清洁空调能让空气中的细菌减少,不产生二次污染。

海尔空调提醒:由于空调蒸发器是翅片结构,用户自己很难自己在家动手清洗干净。有效的空调消毒方法只有两种:要么请专业人士上门清洗,要么使用自清洁空调。
如果您家里是普通空调,则需要请专业的服务人员上门,通过高温高压蒸汽设备彻底冲洗蒸发器。这种人工清洗费用一次在150-200元不等;如果您家里是自清洁空调,则可以开启自清洁功能,彻底清洁蒸发器污垢。

今年以来,为致敬医护人员,海尔空调推出了多项免费上门清洗服务。4月份,海尔空调为援鄂医护人员提供了接风洗尘服务,免费上门清洗脏空调;5月20日至6月10日,又为全体医护人员升级"为爱洗尘 致谢白衣天使"免费清洗服务,为医护人员的健康保驾护航。
除了人工清洗,海尔还在自清洁技术基础上迭代出56度C除菌自清洁空调,自清洁时蒸发器达到56℃并持续30分钟以上,实现高温除菌。海尔空调还在智家APP上线多场"体验云众播",以空调除菌、空气除菌、抑菌新风等3大健康空气场景方案,满足用户的健康呼吸需求。
免责声明:本站为媒体网站,对于商家上传的图片,文字之类版权已采用相关措施进行审核,但不保证其内容的正确性、可靠性,相关责任由上传上述内容的商家负责,特此声明!
网址:中科院细菌实验揭秘:夏天不敢乱开空调,原因都在这了! https://c.jiaju82.com/news-view-id-705647.html

